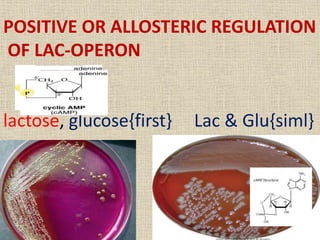
POSITIVE OR ALLOSTERIC REGULATION
OF LAC-OPERON
lactose, glucose{first} Lac & Glu{siml}

Operon concept allows prokaryotes to coordinate gene expression. An operon contains a group of genes that are transcribed together and regulate a metabolic pathway. The lac and trp operons demonstrate induction and repression of gene expression. The lac operon induces expression of lactose-metabolizing enzymes in response to lactose. In the presence of lactose, allolactose acts as an inducer to activate the lac operon. In contrast, the trp operon represses expression of tryptophan-synthesizing enzymes in the presence of tryptophan via a repressor protein. Operons allow prokaryotes to efficiently regulate metabolic pathways in response to environmental conditions.